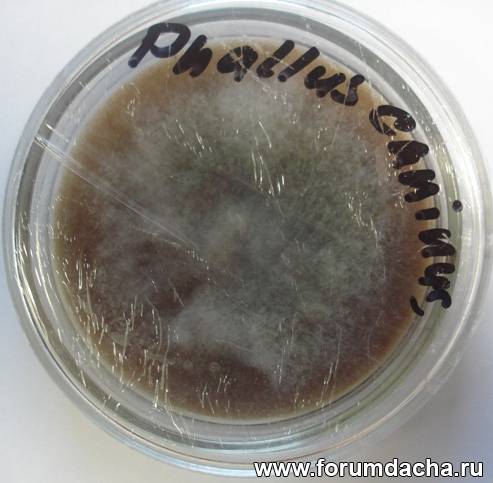
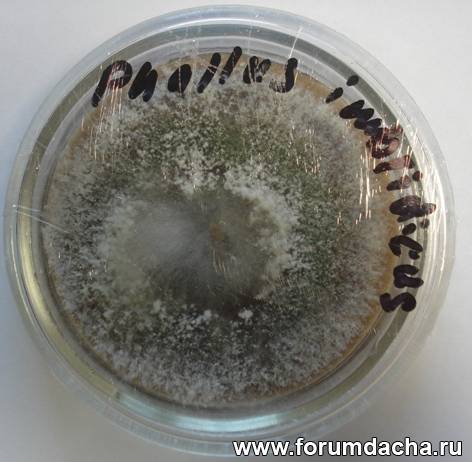
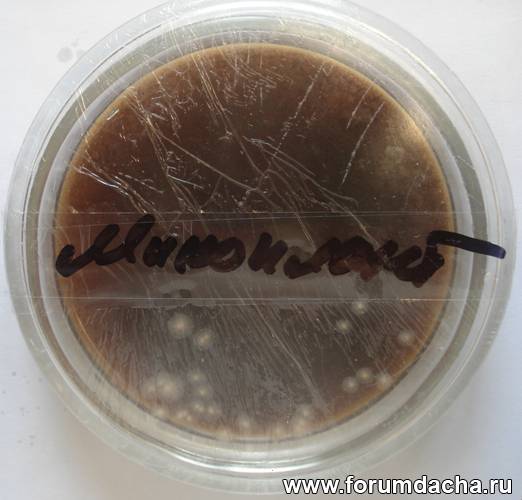

|

| Автор |
Сообщение |
Александр Кузнецов |
|
|
Зарегистрирован: 23.10.2009
Сообщения: 6776
Откуда: Алтайский край, р.ц.Алтайское
|

|
20-06-2012, 17:50 |
 Заголовок сообщения: |
| А.Ю. писал(а): |
Я попробую заразить питательные среды и от спор и от мицелия. Хочу попробовать в качестве питательных сред взять агар, мед и желе гриба. Пара замороженных грибов у меня для этого есть. Один раз но без стерилизации я пробовал заразить желе гриба. Надо сказать на этой среде все росло довольно быстро. Возможно природа и задумала наличие этого желе для размножения...
|
Андрей Юрьевич, я Вам всё же рекомендовал бы воспользоваться рецептом Савелия. То есть, в питательную среду добавить отвар опилок. Чтобы в питательной среде присутствовал "лигнино-целлюлозный комплекс". Потому как высланная Вам Веселка хрящеватая относится к ксилотрофам, то есть пожирателям древесины. А на своем опыте ещё заметил одну особенность по этому грибу. У него явное предпочтение присутствия смородины. Поэтому, сделал бы ещё вытяжку из смородины (веток). И получил бы так называемую элективную среду ((от франц. électif — избранный), то есть попытался бы создать специальные питательные среды, создающие более благоприятные условия для роста определённого вида гриба. А для Веселковых, с вытяжкой из опилок..
Ещё лучше сделайте по своему рецепту как "контроль". Плюс питательную среду с вытяжкой из опилок (отваром). Ну, и если захотите, с вытяжкой из смородины..
Но, это всего лишь совет и рекомендация. А решать Вам.
И не забывайте делиться своим опытом, любым.. Это поможет всем, и избавит от ненужных ошибок в дальнейшем..
Подробнее о наблюдениях за поведением Веселки хрящеватой в теме http://www.forumdacha.ru/forum/viewtopic.php?t=1138&start=80
А ниже специально собрал вместе все сообщения от Савелия по теме, имеющие очень важное практическое значение. Он сейчас в длительной командировке, поэтому не может принять участия в обсуждении. Появится не раньше сентября.
| Савелий писал(а): |
Подготовил агаравую среду и чашки петри...
Рецепт агаровой среды:
агар(900) 15 гр
стакан березовых опилок
2гр сухих дрожжей
10 гр фруктозы
1 литр воды
Варил опилки 30 мин, фильтрование, затем все остальное, долил воды до литра и по чашкам. Стерилизация ЧП. 20 мин в скороварке, остывание и инокуляция. Через 24 часа появился первый пух мицелия, все без заражений. через неделю 1/4 пластины уже было колонизировано. |
| Савелий писал(а): |
".. Но вернемся к чашкам и средам...
Сам мицелий оказался не очень разборчив к агаровым средам, были испробованы бульоны для сред с картофеля,пшеницы, ржи, соломы, все оказалось одинаково хорошим питанием Тепературный режим, на протяжении проводимых опытов был разным. от + 4 С до 25 С.при низких температурах + 4 С, рост мицелия не останавливался, просто происходило сильное замедление его развития. Более плотный мицелий, рос при 15-20 С. . |
| Савелий писал(а): |
.. Опилки даже удачно подобранные должны были пройти какую то предварительную подготовку. Подготовка могла включать в себя такие процессы как длительное замачивание, ферментация природная или искусственная, возможно даже пастеризация с последующей ферментацией. Особенно не радовали сроки приготовления маточного мицелия в таких объемах. Было очевидно, что при той скорости роста которая наблюдалась на агаровых средах, любой объем субстрата может быть колонизирован в гораздо меньшие сроки, надо только создать в субстрате множество точек роста с помощью маточного мицелия.
.. Для старта в эксперименте, первыми были взяты сосновые опилки, я их замочил на двое суток, слил воду и влил в них эмульсию приготовленную из мицелия с агаровой пластины и воды с помощью магнитной мешалки. Для контейнеров были использованы 2-х литровые пластиковые банки. Параллельно кинул в другую банку агаровые клинья с мицелием. В обоих случаях, мицелий в банках взял старт, появился свежи пух и дальше ни какой динамики в росте, потом мицелий просто исчез. Таким же образом были использованы опилки следующих пород древесины: яблоня, клен, тополь, вяз, береза. Результаты были разные но в общем отрицательные, либо очень медленный рост мицелия, причем нитевидного, он рос но складывалось такое впечатление что ему не хватает питания и он пускает свои тяжи в его поисках. Дальше был испробован пастеризованный и стерилизованный субстрат, все с тех же опилок, результат такой же. Когда мицелию субстрат приходится по вкусу, он начинает его колонизировать в точках инокуляции, продвигаясь дальше, обволакивая при этом захваченные участки ровным и плотным слоем, частицы субстрата в районе захвата мицелием пронизаны им полностью. В моем случае этого не происходило.
Дальше в ход пошел зерновой субстрат из пшеницы и ржи, приготовленный по стерильной технологии. Мицелий начинал свой рост в банках, но позже комковался и переставал расти. Позже выход был найден, рожь вперемешку с соломой и стерилизованная 90 мин, показала великолепный результат, банка с объемом субстрата в 1.5 литра заросла полностью за 3 недели. Вот таким образом, потратив относительно не очень много времени, всего около 3-х месяцев, был найден рецепт для маточного мицелия Веселки. С зерновым мицелием, проблем по по наращиванию массы мицелия с помощью разного рода опилок, уже было меньше. За зиму было произведено еще несколько опытов, рожь с соломой оказалась вне конкуренции на фоне других злаков. Опилки для зернового мицелия, подошли все о которых я упоминал выше. Уверен, что подходящих формул рецептов приготовления субстрата, для домашнего выращивания мицелия в домашних условиях, великое множество..
|
| Савелий писал(а): |
Paul
Спасибо за ссылку. Хороший мануал, можно смело брать на вооружение, начинающим микологам 
По субстрату для Веселки в той таблице ни чего нет, поэтому могу добавить, в моих опытах, пастеризация проходила 24 часа при температуре 70 С, затем ферментация/остывание 20 час. в термобоксе из вспененного полистирола. |
| Савелий писал(а): |
На днях продолжил работу, по поиску решений культивации мицелия Веселки. Как и планировал, пробу начал с другого не менее интересного материала-спор Веселки.
Зип-локи в которых находился споровая слизь были изъяты из холодильника. Все содержимое пакетиков в холодильнике, высохло полностью до ломкого состояния. Работу провел следующим образом:
Часть засохшей субстанции размочил, залив в пакетик стерильной водой, набрал в стерильный шприц из зип-лока, уже болотного цвета воду и положил шприц для гидратации спорового материала, на сутки в холодильник. Через положенное время, все содержимое шприца около 20 сс., разлил по банкам с подготовленным субстратом, коим стала стерилизованная рожь. Сейчас эти банки, 3 шт. стоят в темном и теплом месте. Думаю, что если споры сохранили жизнеспособность без своей слизи, то вегетативный рост мицелия, может показаться уже в течении 4-10 дней.
. |
Последний раз редактировалось: Александр Кузнецов (20-06-2012, 19:44), всего редактировалось 1 раз
|
|
А.Ю. |
|
|
Зарегистрирован: 02.05.2011
Сообщения: 182
Откуда: Москва
|

|
20-06-2012, 19:17 |
 Заголовок сообщения: |
Александр Иванович, спасибо. Приму к сведению.
|
|
А.Ю. |
|
|
Зарегистрирован: 02.05.2011
Сообщения: 182
Откуда: Москва
|

|
05-07-2012, 22:19 |
 Заголовок сообщения: |
Пока без фотографий ибо нечем. А как только, так будут и фото.
Рассказываю.
Сделал я главбокс - камеру для проведения работ по внесению спор грибов на питательные среды. Главбокс позволяет дизенфицировать внутренний объем и свести опасность подселения плесени в питательную среду к минимуму. Для главбокса я использовал пластиковый прозрачный ящик с крышкой, в котором проделал два круглых отверстия, в которые вклеил втулки из ПВХ труб для канализации. В эти втулки вставил втулки поменьше диаметром и уже на них одел резиновые перчатки. Также на стенке ящика закрепил кварцевую лампу для убиения жестким излучением всякой гадости.
Приготовление питательной среды.
Купил стеклянные чашки Петри, + использовал имеющиеся мелкие стеклянные баночки.
Был куплен в магазине индийских специй агар.
Были куплены 20 мл шприцы.
Спирт.
Был сварен картофельный отвар. Полная миска мелко нарезанного картофеля варилась минут 40.
Банки для питательной среды протер спиртом. Примерно 1/6 чайной ложки агара насыпал в продезинфицированный шприц, добирал до его полного объема картофельный отвар. Температуру отвара не измерял , наверное от 50 до 80 градасов. Далее тряс шприц до полного растворения агара и затем выливал смесь в баночки. Вылитая смесь не застывала.
Далее на дно скороварки уложил в несколько слоев тряпку. на нее стопкой поставил чашки Петри и другие баночки. налил на дно скороварки воды.. После закипания кипятил под давлением около получаса. Вытащил чашки Петри, дождавшись полного остывания кастрюли.
После последней процедуры после остывания в банках получилось желе.
Поместил банки и чашки Петри в Главбокс. Провел заражение поскоблив над ними тщательно продезинфицированным скальпелем листок с засохшими спорами.
Хочу поблагодарить Александра Ивановича приславшего споровый материал Веселки Хрящеватой и Мутинуса и Александра из Зеленограда, поделившегося плодовыми телами Мутинуса.
Также в магазине я купил пару грибов Лисички (страна происхождения не известна) и натряс спор из них в одну из банок с питательной средой.
Во всех банках на средах ( в том числе и с лисичкой) наблюдается рост мицелия. Пока его очень мало но он виден. Продолжаю наблюдение.
|
|
Александр Дворянинов |
|
|
Зарегистрирован: 30.05.2012
Сообщения: 482
|

|
06-07-2012, 00:13 |
 Заголовок сообщения: |
Андрей Юрьевич, всё вроде правильно, но есть некоторые НО.
Не хочу что бы Вы наступали на грабли, через которые когда то пришлось перешагивать мне. Чашки петри моются обычным мыльным препаратом для мытья посуды, тщательно ополаскиваются, протираются бумажными полотенцами на сухо, и укладываются в ПНД пакет, край пакета завязывается узлом (чтобы пакет плотно обхватывал чашки петри), чтобы при стерилизации в чашках петри не накапливался конденсат (будет, но не значительно).
Разведение питательного раствора следует проводить в небольшой чашке, металлической, наливается отвар картофеля ( в Вашем случае) вводятся остальные желаемые ингредиенты, в последнюю очередь вносится агар (на 100 гр жидкости, 1 ч/л с большим верхом, агара, марки 900). ставится на огонь и подогревается при постоянном помешивании, до начала загустения агара, сливается в ёмкость для стерилизации агара. Агар стерилизуется не в чашках петри а в отдельной ёмкости, и разливается после остывания до 50*С в глав боксе, по чашкам петри, дабы исключить разжижения парами воды при стерилизации, емкость затыкают марлевым тампоном и тампон накрывают фольгой для запекания. После разливания в глав боксе агара, по чашкам петри, им дают отстоятся дня 2-3, для проверки на предмет присутствия заражения, и подсушивания небольшого количества конденсата, образовавшегося после разлива агара, на верхней крышке чашки петри. Если нет роста посторонней плесени за этот период, можно проводит засев спор или вегетативной части мицелия на чашки петри. Вся сложность процесса заключается в том что бы не произошло быстрого роста конкурентов и споры нашей культуры имели возможность прорасти, а затем слится в дикариотический мицелий. Ведь в спорах культуры содержится немало спор конкурентов, вирусов, бактерий, и ещё много всякой гадости. Как и в вегетативном мицелии взятом из под гриба, параллельно с ним растут несколько видов конкурентов, у которых линейный рост превышает в 3-4 раза рост нашей культуры. Для этого и приходится создавать селективные среды, чтобы затормозить рост конкурентов и дать возможность культурному мицелию вырваться вперёд. Лучше всего для получения вегетативного мицелия подходят плодовые тела, а в случае с весёлкой, нужно использовать яйцо, полученный мицелий в точности будет соответствовать исходному материалу при культивировании. Плодовое тело до определённого возраста внутри стерильно, если вырезать из его центра в ламинарном потоке кусочек ткани и поместить на агар, заражений никаких не будет, и можно получить в этом случае, сразу чистую культуру без заражений. Вот так могут выглядеть чашки петри, после внесения спор, на 4-5 день инкубации. В данном случае вырвались только конкуренты, культурного мицелия в чашках петри нет.


|
|
А.Ю. |
|
|
Зарегистрирован: 02.05.2011
Сообщения: 182
Откуда: Москва
|

|
06-07-2012, 11:01 |
 Заголовок сообщения: |
.Александр Дворянинов, Спасибо. Весьма полезно.
Что такое ПНД пакет?
К сожалению марка купленного мною агара не известна. Спрашивал у продавцов - не знают.
|
|
Александр Дворянинов |
|
|
Зарегистрирован: 30.05.2012
Сообщения: 482
|

|
06-07-2012, 11:26 |
 Заголовок сообщения: |
| А.Ю. писал(а): |
.Александр Дворянинов, Спасибо. Весьма полезно.
Что такое ПНД пакет?
К сожалению марка купленного мною агара не известна. Спрашивал у продавцов - не знают. |
ПНД пакет- из полиэтилена низкого давления, свободно выдерживает 1,2 атм. 1ч/л с большим верхом по любому должно хватить на 100 гр раствора.
Последний раз редактировалось: Александр Дворянинов (06-07-2012, 11:41), всего редактировалось 1 раз
|
|
А.Ю. |
|
|
Зарегистрирован: 02.05.2011
Сообщения: 182
Откуда: Москва
|

|
06-07-2012, 11:41 |
 Заголовок сообщения: |
| Александр Дворянинов писал(а): |
| ПНД пакет- из плиэтилена низкого давления, свободно выдерживает 1,2 атм. 1ч/л с большим верхом по любому должно хватить на 100 гр раствора. |
Где такое продается?
Посмотрел в Яндексе. Пакеты ПНД - это обычные полиэтиленовые пакеты?
Упсс.... Похоже как я ни старался, а Чужие проникли в засеваемое пространство. И похоже со спорами.
Последний раз редактировалось: А.Ю. (06-07-2012, 11:45), всего редактировалось 1 раз
|
|
Александр Дворянинов |
|
|
Зарегистрирован: 30.05.2012
Сообщения: 482
|

|
06-07-2012, 11:45 |
 Заголовок сообщения: |
В магазинах, или на базах, используется для фасовки продуктов. Толщиной 8 мкм, вполне достаточно.
Важно определить в какой момент, они туда проникли , до засева или во время, возможно в обоих случаях.
Последний раз редактировалось: Александр Дворянинов (06-07-2012, 11:46), всего редактировалось 1 раз
|
|
А.Ю. |
|
|
Зарегистрирован: 02.05.2011
Сообщения: 182
Откуда: Москва
|

|
06-07-2012, 11:46 |
 Заголовок сообщения: |
| Александр Дворянинов писал(а): |
| В магазинах, или на базах, используется для фасовки продуктов. Толщиной 8 мкм, вполне достаточно. |
Понял. Обычные полиэтиленовые пакеты.
|
|
Александр Дворянинов |
|
|
Зарегистрирован: 30.05.2012
Сообщения: 482
|

|
06-07-2012, 11:47 |
 Заголовок сообщения: |
Полиэтилен есть высокого давления, он не подойдёт.
|
|
А.Ю. |
|
|
Зарегистрирован: 02.05.2011
Сообщения: 182
Откуда: Москва
|

|
06-07-2012, 11:49 |
 Заголовок сообщения: |
Александр Дворянинов, а вы не пробовали перед засеваниеи (инокуляцией) обработать мицелий кварцевой лампой? Не убьет споры излучение? Что более стойкое к нему споры или плесень?
|
|
Александр Дворянинов |
|
|
Зарегистрирован: 30.05.2012
Сообщения: 482
|

|
06-07-2012, 12:05 |
 Заголовок сообщения: |
На споры ультрафиолет не оказывает никакого действия, убивает только вегетативные формы мицелия, воздействуя только на поверхности, в глубине мицелий чувствует себя, вполне благоприятно.
|
|
А.Ю. |
|
|
Зарегистрирован: 02.05.2011
Сообщения: 182
Откуда: Москва
|

|
06-07-2012, 13:40 |
 Заголовок сообщения: |
| Александр Дворянинов писал(а): |
| в глубине мицелий чувствует себя, вполне благоприятно. |
На сколько в глубине?
Споры на листке бумаги сохранятся если облучить кварцевой лампой?
|
|
Александр Дворянинов |
|
|
Зарегистрирован: 30.05.2012
Сообщения: 482
|

|
06-07-2012, 15:13 |
 Заголовок сообщения: |
| А.Ю. писал(а): |
| Александр Дворянинов писал(а): |
| в глубине мицелий чувствует себя, вполне благоприятно. |
На сколько в глубине?
Споры на листке бумаги сохранятся если облучить кварцевой лампой? |
На сколько проникает ультрафиолет, 1-1,5 мм. Не вижу смысла в таком облучении.
|
|
А.Ю. |
|
|
Зарегистрирован: 02.05.2011
Сообщения: 182
Откуда: Москва
|

|
09-07-2012, 12:35 |
 Заголовок сообщения: |
| Александр Дворянинов писал(а): |
| На сколько проникает ультрафиолет, 1-1,5 мм. Не вижу смысла в таком облучении. |
Получается заколдованный круг. Если в спорах присутствуют "Чужие", то заведомо и среда будет ими заражена не смотря на идеальные условия инокуляции и ничего с этим не сделать?
|
|
Paul |
|
|
Зарегистрирован: 03.12.2009
Сообщения: 445
Откуда: Волгоград, Светлый Яр
|

|
09-07-2012, 21:40 |
 Заголовок сообщения: |
| А.Ю. писал(а): |
| Александр Дворянинов писал(а): |
| На сколько проникает ультрафиолет, 1-1,5 мм. Не вижу смысла в таком облучении. |
Получается заколдованный круг. Если в спорах присутствуют "Чужие", то заведомо и среда будет ими заражена не смотря на идеальные условия инокуляции и ничего с этим не сделать? |
Прочтите следующие ссылки и многих вопросов Вам удастся избежать. Вообще любую тему лучше изучать с самого начала.
|
|
А.Ю. |
|
|
Зарегистрирован: 02.05.2011
Сообщения: 182
Откуда: Москва
|

|
10-07-2012, 13:28 |
 Заголовок сообщения: |
Paul, спасибо. Кое что из этого читал. Но еще раз скопировал материал по этим ссылкам.
Из того что я не делал , решение предлагаемое по этим ссылкам - поэтапное переселение части "правильного" проросшего мицелия в новую баночку, отделив правильный от "чужих."
Я же интересовался несколько другим - есть ли способ дезинфицировать мицелий сохраненный тонким слоем на листе бумаги. По этим ссылкам я решения не нашел. Ну или был не внимателен.
|
|
Paul |
|
|
Зарегистрирован: 03.12.2009
Сообщения: 445
Откуда: Волгоград, Светлый Яр
|

|
11-07-2012, 10:51 |
 Заголовок сообщения: |
| А.Ю. писал(а): |
| ...есть ли способ дезинфицировать мицелий сохраненный тонким слоем на листе бумаги? |
Вообще-то трудно сохранить тонкий слой мицелия на листе бумаги. Проще сохранить споры для дальнейшего проращивания.
|
|
А.Ю. |
|
|
Зарегистрирован: 02.05.2011
Сообщения: 182
Откуда: Москва
|

|
11-07-2012, 15:56 |
 Заголовок сообщения: |
Paul Это описка, я имел в виду споры на бумаге. Поспешил - описался.
|
|
Александр Дворянинов |
|
|
Зарегистрирован: 30.05.2012
Сообщения: 482
|

|
12-07-2012, 10:27 |
 Заголовок сообщения: |
| А.Ю. писал(а): |
Получается заколдованный круг. Если в спорах присутствуют "Чужие", то заведомо и среда будет ими заражена не смотря на идеальные условия инокуляции и ничего с этим не сделать? |
Да нет, не заколдованный круг. Вот результат применения антибиотиков, на чашках петри. Дозировка оказалась большой, как для конкурентов, так и для культуры.

А для культуры микопланта нормальной, но не факт что это культура микопланта.

Ещё можно использовать селективные среды, вот пример их использования.
Весёлка хрящеватая

Полёвка

А это культура Микопланта


Но это Вам совершенно не нужно, что бы пользоваться данной методологией, нужно иметь спец оборудование, методологию приготовления и использования, что достаточно не дёшево, и имеет коммерческий интерес для многих микологов.
|
|
|
|
|
|
|
 |
|
Вы не можете начинать темы
Вы не можете отвечать на сообщения
Вы не можете редактировать свои сообщения
Вы не можете удалять свои сообщения
Вы не можете голосовать в опросах
Вы не можете вкладывать файлы
Вы можете скачивать файлы
|
|
|